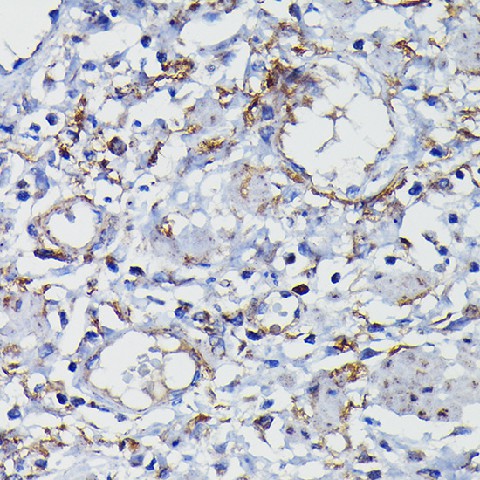
Валидация Elabscience E-AB-90529

| Русское название |
E-AB-90529 Поликлональное антитело к альфа-цепи кластерина <Elabscience,Китай> |
| Каталожный номер |
E-AB-90529 |
| Название антигена |
Clusterin (CLU) |
| UNIPROT |
P10909 |
| Иммуноген |
Рекомбинантный гибридный белок из человеческого Clusterin alpha chain |
| Английские синонимы |
CLU, TRPM2, KUB1, CLI, APOJ, SGP2, AAG4, APO-J, SP-40, Apolipoprotein J, Complement Lysis Inhibitor, 40,Sulfated Glycoprotein 2, Testosterone-Repressed Prostate Message 2 |
| Русские синонимы |
Аполипопротеин J, димерный кислый гликопротеин, репрессируемый тестостероном маркер простаты-2, сульфатированный гликопротеин-2, ингибитор лизиса, опосредованного комплементом |
Реактивность подтвержденная Нужна другая реактивность? |
человек, мышь, крыса |
| Источник (хозяин) |
кролик |
| Изотип |
IgG |
| Клональность |
поликлональное |
| Рекомбинантное |
нет |
| Готовое к использованию |
нет |
| Концентрация |
1мг/мл |
| Конъюгат |
нет |
| Валидировано для |
Иммуногистохимия; Вестерн-блоттинг |
| Рекомендуемые разведения |
WB 1:500-1:2000; IHC 1:50-1:200 |
| Метод очистки |
Аффинная хроматография |
| Состав буфера |
PBS с 0.01% тиомерсал,50% глицерин,pH7.3 |
| Условия доставки |
термобокс с аккумуляторами холода |
| Условия хранения |
Хранить при -20°C - 12 месяцев. Избегать повторяющихся циклов замораживания/оттаивания |
| Срок хранения |
12 месяцев |
| Производитель |
Elabscience |
| Ссылка на страницу товара на сайте производителя |
https://www.elabscience.com/p-clusterin_alpha_chain_polyclonal_antibody-e_ab_90529 |